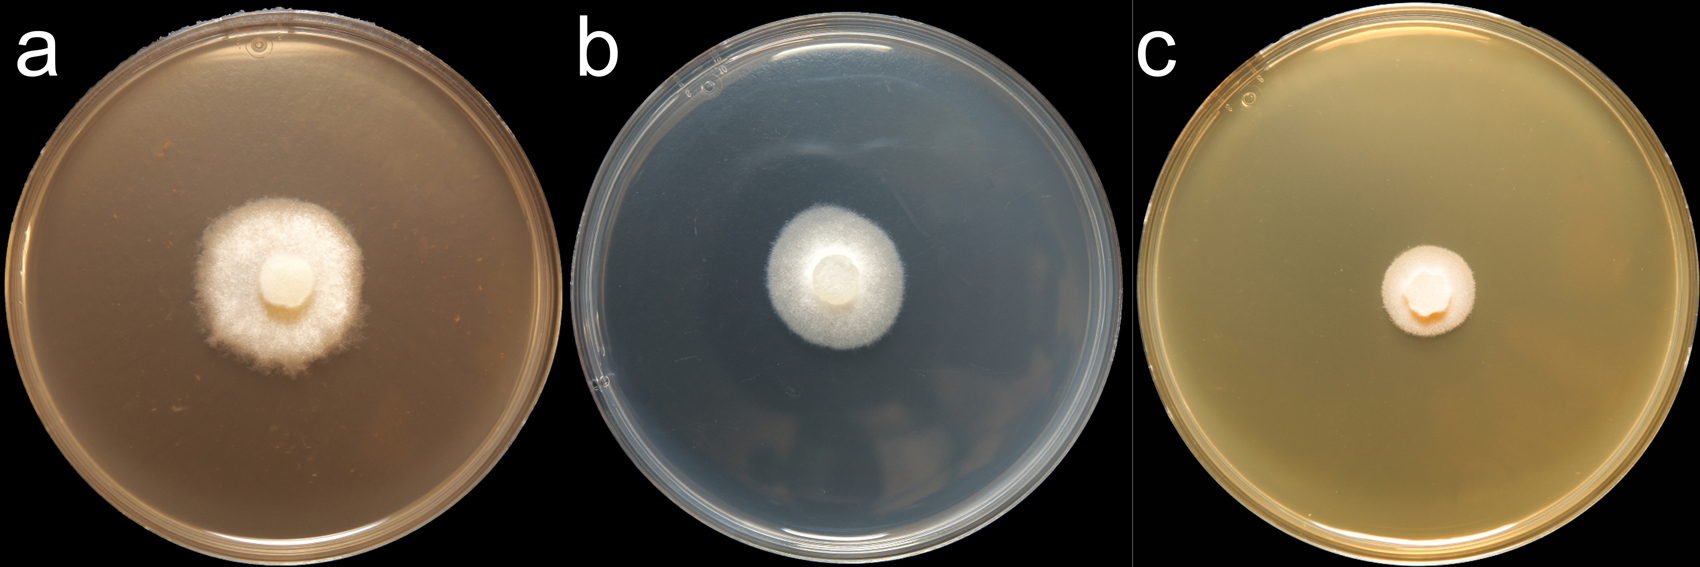

Phytophthora chrysanthemi
|
Phytophthora spp. in subclade 9a: portion of the seven-loci ML phylogeny featuring the type cultures of 212 described species (by T. Bourret). Notice the position of P. chrysanthemi Ex-type CBS 123163 = S&T BL 94. Gloria Abad, USDA S&T.
|
|
Phytophthora spp. in subclade 9a: Morphological Tabular key (PDF) and Tabular key legends (PDF) in IDphy2 KEY SECTION. Notice the data of P. chrysanthemi Ex-type CBS 123163 = S&T BL 94. Gloria Abad, USDA S&T.
|
|
Phytophthora chrysanthemi (CPHST BL 94) colonies of the ex-type grown for 7 days on (a) V8® Agar, (b) potato dextrose agar, and (c) malt extract agar; photo by Krysta Jennings and Leandra Knight, USDA-APHIS-PPQ |
|
Phytophthora chrysanthemi causing root rot of chrysanthemun; slide provided by Koji Kageyama and Meherun Naher, Gifu University, Japan |
|
Phytophthora chrysanthemi (ex-type GF749 - Kageyama) asexual phase sporangia, sporangiophore, and internal proliferation; slide provided by Koji Kageyama and Meherun Naher, Gifu University, Japan
|
|
Phytophthora chrysanthemi (ex-type GF749 - Kageyama) asexual phase, hyphal swellings, and chlamydospores; slide provided by Koji Kageyama and Meherun Naher, Gifu University, Japan |
|
Phytophthora chrysanthemi (ex-type GF749 - Kageyama) sexual phase; slide provided by Koji Kageyama and Meherun Naher, Gifu University, Japan |
Name and publication
Phytophthora chrysanthemi M. Naher, H. Watan., Chikuo & K. Kageyama (2011)
Naher M, Motohash K, Watanabe H, Chikuo Y, Senda M, Suga H, Brasier C, and Kageyama K. 2011. Phytophthora chrysanthemi sp. nov., a new species causing root rot of chrysanthemum in Japan. Mycol. Prog. 10: 21–31.
Corresponding author: kageyama@green.gifu-u.ac.jp
Nomenclature
from Naher et al. (2011)
Mycobank
Etymology
refers to the original host plant of this pathogen
Typification
Type: JAPAN, Gifu, Minokamo (36°N, 137°E), from root rot of potting chrysanthemum (Chrysanthemum X morifolium), 2000, collector H. Watanabe, isolate NBRC 104917 (deep-freezing) deposited at the National Institute of Technology and Evaluation - Biological Resource Center, Japan
Ex-type: CBS 123163 = GF749
Sequences for ex-type in original manuscript: Phytophthora chrysanthemi GF749 = ITS AB437135, β-tub AB511995, TEF 1α AB511925, LSU AB465349, HS 90 AB511987, L10 AB511926
Ex-type in other collections
(ET) CBS 123163, S&T BL 94 (Abad), GF749, 61F1 (Hong)
Molecular identification
Voucher sequences for barcoding genes (ITS rDNA and COI) of the ex-type (see Molecular protocols page)
Phytophthora chrysanthemi isolate CPHST BL 94 (= P19843 WPC) = ITS rDNA MG865472, COI MH136868
Voucher sequences for Molecular Toolbox with seven genes (ITS, β-tub, COI, EF1α, HSP90, L10, and YPT1
(see Molecular protocols page) (In Progress)
Voucher sequences for Metabarcoding High-throughput Sequencing (HTS) Technologies [Molecular Operational Taxonomic Unit (MOTU)]
(see Molecular protocols page) (In Progress)
Sequences with multiple genes for ex-type in other sources
- NCBI: Phytophthora chrysanthemi CPHST BL 94
- NCBI: Phytophthora chrysanthemi GF749
- BOLDSYSTEMS: Phytophthora chrysanthemi (barcoding COI & ITS)
Position in multigenic phylogeny with 7 genes (ITS, β-tub, COI, EF1α, HSP90, L10, and YPT1)
Clade 9a
Morphological identification
adapted from Naher et al. (2011)
Colonies and cardinal temperatures
Colonies on V8-A, PDA, and MEA with no distinctive pattern. Minimum temperature for growth 6°C, optimum 30°C, and maximum 35°C.
Asexual phase:
SporangiaSporangia:
sac within which zoospores form, especially when water is cooled to about 10°C below ambient temperature; in solid substrates, sporangia usually germinate by germ tubes
nonpapillatenonpapillate:
pertaining to the production of a non-distinct, or inconspicuous, papilla at the distal end of the sporangium (cf. papillate and semipapillate)
; persistentpersistent:
pertaining to sporangia that remain attached to the sporangiophore and do not separate or detach easily (cf. caducous)
; ellipsoidellipsoid:
refers to a solid body that forms an ellipse in the longitudinal plane and a circle in cross section; many fungal spores are ellipsoidal or elliptic
, ovoidovoid:
egg-shaped, with the widest part at the base of the sporangium and the narrow part at the apex
, or pyriformpyriform:
pear-shaped, with the narrowest part at the base (cf. obpyriform)
(24–59 μm long ×16–43 μm wide); with extended, nested, or internal proliferationinternal proliferation:
internal proliferation occurs when the sporangiophore continues to grow through an empty sporangium
with 3 to 8 sporangiasporangia:
sac within which zoospores form, especially when water is cooled to about 10°C below ambient temperature; in solid substrates, sporangia usually germinate by germ tubes
. SporangiaSporangia:
sac within which zoospores form, especially when water is cooled to about 10°C below ambient temperature; in solid substrates, sporangia usually germinate by germ tubes
produced in single or sympodial sporangiophores. Hyphal swellings elongated, irregular to globoseglobose:
having a rounded form resembling that of a sphere
, produced lateral and intercalaryintercalary:
positioned within a hypha (cf. terminal)
(up to 67 μm). ChlamydosporesChlamydospores:
an asexual spore with a thickened inner wall that is delimited from the mycelium by a septum; may be terminal or intercalary, and survives for long periods in soil
spherical terminal, lateral, or intercalaryintercalary:
positioned within a hypha (cf. terminal)
(27–46 μm diam.).
Sexual phase
Homothallichomothallic:
pertaining to sexual reproduction that can take place within a single thallus (i.e. self-fertile, non-outcrossing) (cf. heterothallic).
. OogoniaOogonia:
the female gametangium in which the oospore forms after fertilization by the antheridium
terminal, often laterally sessile and intercalaryintercalary:
positioned within a hypha (cf. terminal)
with smooth walls; mostly spherical or nearly spherical, and occasionally possessing a distinct funnel-shaped stalk (26–46 μm diam.), acquiring a golden brown color with aging; antheridiaantheridia:
the male gametangium; a multinucleate, swollen hyphal tip affixed firmly to the wall of the female gametangium (the oogonium)
mostly terminal and occasionally intercalaryintercalary:
positioned within a hypha (cf. terminal)
and predominantly paragynousparagynous:
pertaining to the sexual stage in which the antheridium is attached to the side of the oogonium (cf. amphigynous)
but sometimes amphigynousamphigynous:
pertaining to the sexual stage in which the antheridium completely surrounds the stalk of the oogonium (cf. paragynous)
; oosporeoospore:
zygote or thick-walled spore that forms within the oogonium after fertilization by the antheridium; may be long-lived
apleroticaplerotic:
pertaining to a mature oospore that does not fill the oogonium; i.e. there is room left between the oospore wall and oogonium wall (cf. plerotic)
, spherical (19–35 μm diam.).
Additional specimen(s) evaluated
Phytophthora chrysanthemi CPHST BL 94 = P19843 (World Phytophthora Collection)
Hosts and distribution
Distribution: Asia (Japan), Europe (Croatia, Germany), North America (USA)
Substrate: stems, roots
Disease note: stem and root rot
Hosts: Chysanthemum (Asteraceae)
Retrieved January 29, 2018 from U.S. National Fungus Collections Nomenclature Database.
Quarantine status
Phytophthora chrysanthemi is listed in the U.S. Regulated Plant Pest Table (last modified Nov. 15, 2017).
Additional references and links
- SMML USDA-ARS: Phytophthora chrysanthemi
- EPPO Global Database: Phytophthora chrysanthemi
- Forest Phytophthoras of the world: Phytophthora chrysanthemi
- CABI Digital Library: Phytophthora chrysanthemi
- Encyclopedia of Life (EOL): Phytophthora chrysanthemi
- Index Fungorum (IF): Phytophthora chrysanthemi
- Google All Phytophthora chrysanthemi
- Google Images Phytophthora chrysanthemi
- Google Scholar Phytophthora chrysanthemi
Fact sheet author
Z. Gloria Abad, Ph.D., USDA-APHIS-PPQ-S&T Plant Pathogen Confirmatory Diagnostics Laboratory (PPCDL), United States of America.